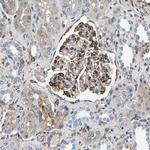
DUSP8 Antibody in Immunohistochemistry (Paraffin) (IHC (P))

Search
Invitrogen
DUSP8 Polyclonal Antibody
{{$productOrderCtrl.translations['antibody.pdp.commerceCard.promotion.promotions']}}
{{$productOrderCtrl.translations['antibody.pdp.commerceCard.promotion.viewpromo']}}
{{$productOrderCtrl.translations['antibody.pdp.commerceCard.promotion.promocode']}}: {{promo.promoCode}} {{promo.promoTitle}} {{promo.promoDescription}}. {{$productOrderCtrl.translations['antibody.pdp.commerceCard.promotion.learnmore']}}
产品信息
PA5-82712
种属反应
宿主/亚型
分类
类型
抗原
偶联物
形式
浓度
规格
纯化类型
保存液
内含物
保存条件
运输条件
RRID
产品详细信息
Immunogen sequence: SDDAYRFVKD RRPSISPNFN FLGQLLEYER SLKLLAALQG DPGTPSGTPE PPPSPAAGAP LPRLPPPTSE SAATGNAAAR
Highest antigen sequence indentity to the following orthologs: Mouse - 84%, Rat - 84%.
靶标信息
The protein encoded by this gene is a member of the dual specificity protein phosphatase subfamily. These phosphatases inactivate their target kinases by dephosphorylating both the phosphoserine/threonine and phosphotyrosine residues. They negatively regulate members of the mitogen-activated protein (MAP) kinase superfamily (MAPK/ERK, SAPK/JNK, p38), which is associated with cellular proliferation and differentiation. Different members of the family of dual specificity phosphatases show distinct substrate specificities for various MAP kinases, different tissue distribution and subcellular localization, and different modes of inducibility of their expression by extracellular stimuli. This gene product inactivates SAPK/JNK and p38, is expressed predominantly in the adult brain, heart, and skeletal muscle, is localized in the cytoplasm, and is induced by nerve growth factor and insulin. An intronless pseudogene for DUSP8 is present on chromosome 10q11.2.
仅用于科研。不用于诊断过程。未经明确授权不得转售。
篇参考文献 (0)
生物信息学
蛋白别名: Dual specificity protein phosphatase 8; Dual specificity protein phosphatase hVH-5; FLJ42476; FLJ42958; H1 phosphatase, vaccinia virus homolog; OTTHUMP00000164487; serine/threonine specific protein phosphatase; unnamed protein product
基因别名: C11orf81; DUSP8; HB5; HVH-5; HVH8; VH5
UniProt ID: (Human) Q13202
Entrez Gene ID: (Human) 1850